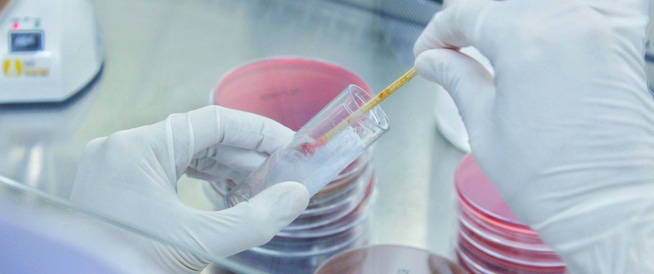

البلغم (Sputum) هو عبارة عن مادة تتكون من لعاب ومخاط تصل إلى الفم نتيجة للسعال، حيث أن مصدرها هو من الرئتين، من الرغامى (القصبة الهوائية – Trachea) أو الشعب الهوائية (Bronchi).
هذه الإفرازات قد تكون ملوثة، نتيجة لعوامل ممرضة (مسببة للمرض – Pathogenic) مختلفة، قد تكون دموية، أو قد تحتوي على خلايا مختلفة يمكن بواسطتها تشخيص أمراض رئوية مختلفة وعوامل ملوِّثة (عدوائية) مختلفة، مثل التهابات الرئة (Pneumonia)، السل (Tuberculosis)، مرض الاٍيدز (متلازمة العوز المناعي المكتسب – AIDS) وسرطان الرئة.
فحص البلغم هو ليس فحصا باضعا (Invasive)، وينطوي على أهمية كبرى للإجراءات الطبية التالية:
العامل المسبب للالتهابات الرئوية قد يكون جرثوميا، فيروسيا أو فطريا.
نتائج فحص البلغم تنطوي على أهمية كبيرة لتشخيص مسببات التلوث المختلفة، مثل التهابات الرئة، السل ومرض الايدز، وكذلك لتشخيص الإصابة بسرطان الرئة.
يمكن أخذ عينة من البلغم بعد سعال المريض. لدى المرضى الذين لا يستطيعون إخراج بلغم بقواهم الذاتية، يجب تحريض (تحفيز) المسالك الهوائية بواسطة استنشاق محلول ملحي من أجل الحصول على عينات من مناطق أكثر عمقا في الشعب الهوائية.
فحص البلغم بهذه الطريقة يسمى بـ “البلغم المحدَث (أو: المحرَّض)”. يمكن تحديد مصدر العينة حسب نوع الخلايا الموجودة في داخلها، إذ يمكن تمييز العينة التي أخذت من الشعب الهوائية العميقة إذا تبين وجود بلاعم وخلايا التهابية أخرى فيها، بينما يمكن تمييز العينة التي أخذت من القسم العلوي من الشعب الهوائية إذا تبين وجود خلايا ظهارية (Epithelia) كثيرة فيها.
يجب فحص البلغم قبل إعطاء / تناول أي علاج للبلغم من شأنه أن يمنع تكاثر الجراثيم، الفيروسات أو الفطريات. عينة البلغم الأكثر موثوقية ومصداقية هي تلك التي يتم أخذها في الصباح، أُثناء الصوم، وبعد استنشاق عميق وسعال قوي.
تطبيق فحص ” البلغم المُحْدَث” (أو: البلغم المُحَرَّض – Induced sputum) بعد استنشاق محلول ملحي (ماء مالح):